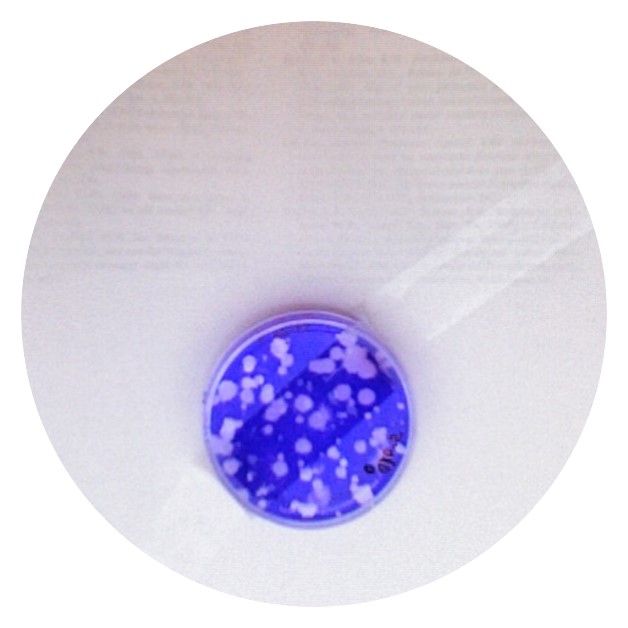
Slide 1

| Former Students and Post-Doctoral Scholars |
 |
 |
 |
| Hannes Schenk |
|
|
| Visiting PhD student |
|
|
|
Hannes worked on modeling SARS-CoV-2 RNA in wastewater across the United States.
|
|
|
 |
 |
 |
| Jacob Phaneuf |
Lorelay Mendoza |
Claire Anderson |
| MS 2022 |
PhD 2025 |
PhD 2023, Post doc 2025 |
|
Jacob did field work on the beach microbiome and coastal water quality.
|
Lorelay worked on wastewater surveillance and also with Will Tarpeh.
|
Claire working on a wide range of topics including enveloped viruses in the environment and soil transmitted helminths.
|
 |
 |
 |
| Lauren Kennedy |
Katie Langenfeld |
Suzy Kim |
| Post doc 2024 |
Post doc 2023 |
PhD 2023 |
|
Lauren studied norovirus persistence in the environment and worked on wastewater-based epidemiology.
|
Katie studied the beach microbiomor at Stinson Beach.
|
Suzy worked on wastewater-based epidemiology.
|
 |
 |
 |
| Laura Roldan |
Winnie Zambrana |
Ryan Searcy |
| PhD 2024 |
PhD 2024 |
PhD 2023 |
|
Laura studied the partitioning of viruses to wastewater solids, and the persistence of viruses in wastewater.
|
Winnie studied handwashing to remove viruses from hands, as well as wastewater based epidemiology. She also studied viruses on fomites.
|
Ryan worked on modeling of pathogens, pathogen indicators, and environmental DNA in the coastal ocean.
|
 |
 |
 |
| Wiley Jennings |
Stephanie Loeb |
Katy Graham |
| PhD 2020 |
Post doc 2020 |
PhD 2021 |
|
Wiley studied fecal pollution in environmental waters. His projects included working with citizen scientists to sample coastal discharges, modeling environmental factors associated with fecal pollution in San Francisco waters, human virus in environmenal waters in Chile, and investigating the persistence of human norovirus in surface waters.
|
Stephanie studied the photoinactivation of norovirus in natural waters. Her work aimed to develop qPCR methods for predicting infectivity after sun exposure and to improve the mechanistic understanding of the sunlight inactivation mechanisms in human norovirus. |
Katy worked on several different projects on the role of sea spray in the beach microbiome and a QMRA of MST markers at California beaches. She also studied viral pathogens in stormwater and their removal in biofilters and other LID.
|
 |
 |
 |
| Marlene Wolfe |
Mhara Coffman |
David Catoe |
| Postdoc 2021 |
MS 2022 |
Technician 2021 |
|
Marlene worked on projects related to SARS-CoV-2 RNA in wastewater as well as persistence of enveloped viruses on fomites and hands.
|
Mhara worked on detection of SARS-CoV-2 RNA in wastewater on Stanford Campus.
|
David is a measurement expert in molecular methods and worked on measuring SARS-CoV-2 RNA in wastewater project.
|
 |
 |
|
| Ben Kranner |
Jill McClary |
Eily Andruszkiewicz |
| ENG 2019 |
PhD 2018 |
PhD 2019 |
| Ben was an MS/ENG degree student working on stormwater biofilters. |
Jill was a PhD student who studied how enteric and pathogenic bacteria respond to sunlight exposure in seawater. Her work focuses primarily on Staphylococcus aureus. She used cell transcripts to better understand how they respond to photo stress. She received her BS from University of Illinois (UIUC). She is now a post doc at the School of Freshwater Sciences at the University of Wisconsin-Milwaukee. |
Eily was a masters/PhD student who studied environmental DNA in the marine environment. She completed her BS at Notre Dame and studied eDNA in freshwater. You can find Eily in the woods on the weekends, often with her siblings (big brother Pete in picture)! She recently was awarded an EPA-STAR grant for her PhD research. She is now a post-doc at Woods Hole Oceanographic Institute (WHOI). |
 |
 |
 |
| Collin Closek |
Nabiul Afrooz |
Dan Reineman |
| Post-Doctoral Scholar 2019 |
Post-Doctoral Scholar |
|
| Collin was an Early Career Science Fellow at the Center for Ocean Solutions. He is examining biodiversity from the Monterey Bay and Florida Keys National Marine Sanctuaries. As part of the Marine Biodiversity Observation Network (MBON), he worked to optimize molecular tools to examine environmental DNA (eDNA) in the water column. Collin earned his PhD from Penn State in 2014 and his BS in Biology from the University of Georgia. |
Nabiul worked in the Urban Water ERC ReNUWIt. He investigated the long-term efficiency of biochar as a filtration media in removing pathogens from stormwater to aid optimization of the field scale design of bioinfiltration systems for urban stormwater treatment. Nabiul has received his PhD from UT Austin in 2015. He is originally from Bangladesh and did his Bachelors in Civil Engineering from BUET. He is now working at the CA state water board in Sacramento. |
Dan worked on on an NSF-funded project to engage citizens in coastal water quality monitoring. To learn more about the study, visit this link: beach.stanford.edu. Dan is now a professor at California State University Channel Islands. |
|
|
 |
 |
| Lauren Steinbaum |
Kendra Brown |
Mia Mattioli |
| PhD 2017 |
PhD 2016 |
PhD 2015 |
| Lauren was a PhD student studying soil-transmitted helminth egg contamination in households in rural Kenya. She is now at University of Georgia. |
Kendra was a PhD student studying the transport and fate of microbial pollutants in beach sands and seawater. She is now working at the University of Massachusetts Amherst. |
Mia did her PhD and a post doc in the lab. She studied water, hands, and health in developing countries, as well as persistence of molecular markers of fecal pollution in water. She was a post doc at Emory. She is now working at the CDC in Atlanta. |
 |
 |
 |
| Angela Rice |
Lauren Sassoubre |
Peter Maraccini |
| PhD 2015 |
PhD 2014 |
PhD 2016 |
| Angela studied water, hands, and health in developing countries. In the picture at the right, she is making a biscuit on a stick while camping. She is currently a teaching fellow at Stanford for the Thinking Matters program. |
Lauren was a PhD student and post doctoral scholar in the lab. She was studying the use of eDNA to detect fish in the ocean for her post doc. For her PhD, she studied the effect of sunlight on enterococci in seawater. She is now a professor at University of Buffalo . |
Peter studied sunlight inactivation of microorganisms in water. He now lives in Southern California and works for a small environmental engineering company. |
|
|
|
|
| Anthony Wai Thoe |
Dan Wang |
Sanjay Mohanty |
| Post-Doctoral Scholar |
Post-Doctoral Scholar |
PhD 2011 |
| Anthony was a post doctorial scholar working on a project to model beach water quality along the State of California coastline. Anthony previously worked on a similar project in Hong Kong where he is from and attended graduate school. Anthony now is a beach manager in Hong Kong. |
Dan was a post doctorial scholar working on the State of California source identification project to identify sources of microbial pollution along the coast line. She received her PhD from UC Davis in 2011 and is from China. She now works for the EPA. |
Sanjay was a post doctorial scholar working in the Urban Water ERC ReNUWIt. He studied how to best design bioinfilitration systems for the removal of pathogens in stormwater. Sanjay received his PhD from University of Colorado Boulder and is originally from India. He completed a post doc at University of Pennsylvania working after leaving Stanford. He is now an assistant professor at UCLA. Here is a link to his website. |
|
|
|
|
| Kevan Yamahara |
Todd Russell |
Simon Wong |
| PhD 2011, COS Early Career Fellow |
PhD 2014 |
PhD 2014 |
| Kevan studied enterococci and E. coli in beach sand along the California Coast. Kevan used to be a professional fisherman and is an avid surfer. He was awarded a position at the Center for Ocean Solutions as an early Career Scholar to work with Boehm and Chris Scholin at MBARI to adapt the environmental sample processor to measure concentrations of fecal indicators and pathogens. He is now working full time at MBARI. |
Todd studied the transport of E. coli, enterococci, and coliphage through sands as well as within the surfzone. He led the microbial source tracking project at Cowell Beach, Santa Cruz, CA as part of the State of California Source Identification project. He is currently the vice president of System Operation Servises, Inc (SOS). |
Simon studied at the intersection of fluid mechanics with water quality science. He studied the effect of internal tides on shoreline water quality at Huntington Beach, CA. He also studied the fate of small plumes in the coastal ocean. Simon currently lives in his home country of Hong Kong. |
|
|
|
 |
| Amy Pickering |
Nick de Sieyes |
Blythe Layton |
| PhD 2011 |
PhD 2011 |
PhD 2011 |
| Amy was a doctoral student in the IPER program where she studied the efficacy of alcohol-based hand sanitizer for reducing bacteria and pathogen concentrations on hands, and improving health in the developing world. Amy is now a research associate at Stanford and works on projects in Kenya, Mali, Bangladesh, and Tanzania. She will soon begin as a professor at Tufts. |
Nick was a California Sea Grant trainee. He studyed submarine groundwater discharge along wave-dominated California beaches. In the picture at the left, he is installing well points at our field site at Huntington Beach, Ca. (Nick is on the beach, Keeney Willis is on the ladder.) Nick currently works at UC Davis. |
Blythe studied enterococci in the environment and the relation between climate and health. |
|
|
|
|
| Sarah Walters |
Emily Viau |
Tim Julian |
| Post-Doctoral Scholar |
Post-Doctoral Scholar |
PhD 2010 |
| Sarah studyed the persistence of nucleic acids in natural waters. In particular, she was working with poliovirus and enterococci. Her poliovirus plaque assay is shown at the right. She also ran the USDA project to look at pathogens and indicators in coastal streams. |
Emily studied the health risk of exposure to land based runoff from streams in Hawaii. Her work was funded by the NSF Oceans and Human Health program. She also assisted in the Tanzania project with the microbiology and pathogen testing of water and hand rinse samples. Emily received her PhD from Yale in 2009 studying pathogens in biosolids. |
Tim's thesis is entitled Fomites in Infectious Disease Transmission: A modeling, laboratory, and field study on microbial transfer between skin and surfaces. He was a post doc in Kellog Schwab's group at Johns Hopkins School of Public Health in Baltimore and is now a professor at EAWAG in Zurich, Switzerland. |
 |
 |
|
| Karen Knee |
Maggie Montgomery |
Daniel Keymer |
| PhD 2010 |
Post-Doctoral Scholar 2009 |
PhD 2009 |
| Karen was a doctoral student in geology and environmental sciences. She was co-advised by Adina Paytan and Ali Boehm. She studied submarine groundwater discharge along the Kona coast of Hawaii and the North shore of Kauai (in Hanalei). She was a Fulbright Scholar working in Ecuador and is now a professor at American University in Washington DC. |
Maggie worked on the Tanzania project to understand how providing personalized information on water quality and hand contamination influences people's behaviors and attitudes about water, as well as their health and stored water quality, and hand contamination. She is currently working on international water and health issues at the WHO in Geneva. |
Daniel studied the ecology of Vibrio cholerae in California coastal waters. Daniel was the recipient of a Stanford Graduate Fellowship. In the photo to the left, Daniel collects data during one of his monthly sampling outings. Daniel was a post doc at University of Illinois at Urbana-Champaign as well as University of Georgia. He is now a professor at University of Wisconsin Stevens Point. |
|
|
|
 |
| Alyson Santoro |
Nick Handler |
Deyi Hou |
| PhD 2008 |
MS with Thesis 2006 |
MS/ENG |
| Alyson studied the microorganisms responsible for nitrogen cycling in coastal aquifers and how sea surface temperature and other ocean physics controls pollutant and phytoplankton levels in the surf zone. In this picture, she is collecting samples from the surf zone at day break during August of 2005. Alyson was the recipient of an NSF Graduate fellowship. A culture of ammonia oxidizing bacteria and archaea she collected and grew from the subsurface at Huntington Beach is shown to the right. Alyson is a post doctoral researcher at Woods Hole Oceanographic Institute. She was a professor at Horn Point Marine Lab in Maryland and is now a professor at UCSB. She is the proud owner of a german shepard. |
Nick studied the effect of land use on coastal water quality in central and northern California. He is currently working in the lab as a researcher. Nick's sampling sites are shown to the right. Nick now lives in Uganda where he works for One Acre Fund. |
Deyi received his MS and ENG degrees. His work focused on risk endured from recreational water contact. He is also studyed the ecology of fecal indicator bacteria and Salmonella spp. in seawater. He was the recipient of the Shaw Fellowship from Stanford University. |
 |
 |
 |
| Francisco Tamayo |
Diana Kitt |
Lilian Lam |
|
|
|
| Francisco was a high school student who worked in the lab. He worked with Kevan Yamahara studying enterococci persistence in sand. He attended Eastside Prep in East Palo Alto where he was a resident at one of the dormatories. He is an amazing artist and musician! His talents never cease to amaze us! |
Diana was a undergraduate student researcher participating in the ReNUWIt REU program in summer of 2016. She worked on biofilters for removal of pathogens from stormwater. At the time, she was a rising senior at University of Delaware majoring in CEE. |
Lilian was a high school senior when she started in the lab. She attends Swarthmore College. She has worked with Daniel Keymer and Blythe Layton. During the summer of 2006, she investigated the variability in Vibrio cholerae across a salinity. During the summer of 2007, she worked with Blythe to study the esp gene in enterococci and what species of enterococci can be found in the environment. She is a whiz at molecular methods and might just be the most productive member of the lab. She recently received her PhD from at Stanford in the Microbiology Department and now has a post doctoral position in the UK. |